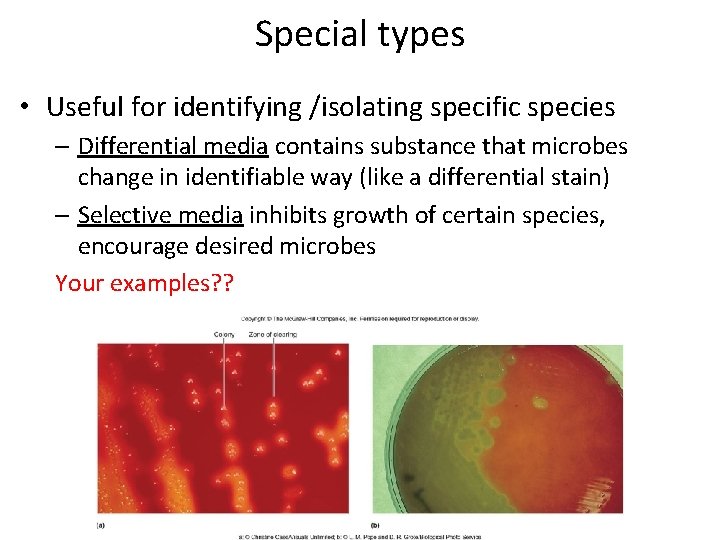
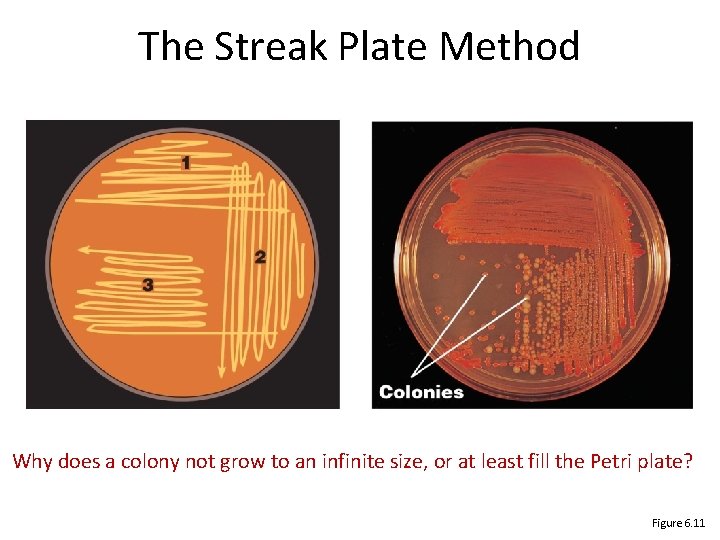

Bio 260 Bacterial growth Chapter 6 MICROBIAL GROWTH

Bio 260 Bacterial growth

Chapter 6 MICROBIAL GROWTH Integrate: basics, structure, chemistry, practical application of metabolism

A definition • Growth - it’s all about the numbers • An increase in population size

Lab basics Petri dish – 10 cm diameter = ? mm a “colony” - ~ 1/35 th = 3 mm VISIBLE A bacterium is - ~ 1 -10 um INVISIBLE = how many times smaller? How many cells? Each colony begins with 1 cell dividing many, many times How long?

How did we get here? • German physician Robert Koch (1843 -1910) – You know him from earlier in the quarter – Studied pathogenic bacteria; Nobel Prize 1905 – Developed methods of cultivating bacteria – Solid medium attempts (1 cell colony) • Tried gelatin, melted easily, and got EATEN – 1882 Fannie Hess, wife of colleague • Suggested agar, used to harden jelly

Where are we now? • Prokaryotes found growing in severe conditions – Ocean depths, volcanic vents, polar regions all harbor thriving prokaryotic species – Many scientists believe that if life exists on other planets, it may resemble these microbes • Individual species have limited set of conditions – Also require appropriate nutrients • Important to grow microbes in culture – Medical significance – Nutritional, industrial uses

Four questions • • What are the principles of microbial growth? What conditions do microbes need to grow? How can we grow microbes in the lab? How can we measure growth? • Goal: how can we control growth to prevent spoilage, infection, gauge environmental status, or promote industrial uses?

What are the principles of microbial growth? • How do we increase the population size? • Single-celled microbes – Bacteria, Archae; some Fungi (yeast) – asexual reproduction – Binary fission • For comparison – Sexual reproduction – single /multi-celled organisms

Reproduction in Prokaryotes • • Binary fission – most bacteria, some yeasts Budding Conidiospores (actinomycetes) Fragmentation of filaments

Binary Fission • One cell divides into two, 2 4, 4 8, 8 16, etc… • Exponential growth: population doubles every division • Generation time is time it takes to double • Varies among spp, • affected by environment • E coli = 20’ • “four hour rule” • Food at RT no more than 4 h • 10 cells pathogen in food 40, 000 cells in 4 hours Figure 6. 12 a

Growth can be calculated • Nt = N 0 x 2 x • Nt = number of cells in population at time t • N 0 = original number of cells in population • x = number of divisions • eg. : pathogen in potato salad at picnic in sun • • • Assume 10 cells with 20 minute generation time N 0 = 10 cells in original population x = 12 (3 divisions per hour for 4 hours) Nt = N 0 x 2 x = 10 x 212 Nt = 10 x 4, 096 Nt = 40, 960 cells of pathogen in 4 hours!

Financial analogy You win the (world’s strangest) lottery with two options Option 1: get $10, 000 every day for a month Option 2: get a penny that doubles daily for a month IN PAIRS: Each of you pick a scenario, do the math for the first 10 days, compare outcomes, choose together

Financial analogy You win the (world’s strangest) lottery with two options Option 1: get $10, 000 every day for a month 30 days x $10, 000 = $300, 000 Option doubles daily for a month Day 2: get a penny that pennies 1000 x every 10 doublings After 10 days you have $10 After 20 days ~$10, 000 30 230 After 30 days ?

Bacterial growth is like this* The power of exponential growth: Rapid generation time can yield huge populations quickly Remember that generation time depends on species and growth conditions *under ideal environmental conditions… How long to make a colony of E coli under ideal conditions: 20 x 20’ =7 h

Graphing the raw numbers is a pain Unless you use a log scale

Graphing bacterial growth on a log scale *under ideal environmental conditions… Figure 6. 14

Phases of Growth Figure 6. 15

The Growth Curve • Lag Phase – Delay, variable; number of cells does not increase – Begin synthesizing enzymes required for growth • Log (exponential) Phase – Cells divide at constant rate generation time measured – Most sensitive to antibiotics • Stationary Phase – Nutrient levels too low to sustain growth – Total numbers constant Some die, release contents; others grow • Death Phase – – Total number of viable cells decrease Cells die at constant rate Exponential, but usually much slower than cell growth Some fraction may survive - adapted to worsened conditions

Colony Growth • Colonies and liquid cultures share similarities • Important differences based on location – Position of cell determines its environment ie conditions – Edge of colony has O 2, nutrients – Center of colony has depleted O 2, nutrients • Accumulation of potentially toxic wastes including acids – Colony may have log phase at edges, death phase in center

What conditions do microbes need? • • • Temperature p. H Water/ osmotic pressure Oxygen/ detox Nutrients

Temperature • • • Groups based on temperature requirements Minimum growth temperature Optimum growth temperature Maximum growth temperature Why is the graph shaped this way?

Classify based on temp. requirements • Each species has well-defined temperature range – Optimum growth usually close to upper end of range – Psychrophile: -5° to 15°C • Polar regions – Psychrotroph: 20° to 30°C • Food spoilage – Mesophile: 25° to 45°C • Pathogens 35° to 40°C – Thermophiles: 45° to 70°C • Common in hot springs – Hyperthermophiles: 70° to 110°C • Usually Archaea • Hydrothermal vents Why aren’t there microbes with broader ranges?

Food Preservation Temperatures Psychrotrophs: §Grow between 0°C and 20– 30°C §Cause food spoilage Are food spoilage organisms the same as pathogens typically? Figure 6. 2

Consequences of temp requirements • Temperature and Food Preservation – Fridge (~4°C) slows spoilage by limiting growth of otherwise fast-growing mesophiles • Psychrophiles, psychrotrophs can still grow, but slowly – Freezing preserves food; not effective at killing microbes • Temperature and Disease – Temperature of different parts of human body differs • Some microbes cause disease in certain parts • E. g. , Hansen’s disease (leprosy) involves coolest regions (ears, hands, feet, fingers) due to preference of M. leprae

p. H • • • Predict: bacteria grow best near p. H ? Neutral p. H 7 (there are exceptions) Molds and yeasts grow between p. H 5 and 6 Why is p. H important? A reminder: p. H is the negative log of [H+] p. H 2 vs p. H 4 more acid or more basic? how much more?

p. H • Bacteria survive a range of p. H; have optimum – Most microbes are neutrophiles • Range of p. H 5 to 8; optimum near p. H 7 • Food can be preserved by increasing acidity • H. pylori grows in stomach; produces urease to split urea into CO 2 and ammonia to decrease acidity of surroundings – Acidophiles optimal p. H < 5. 5 • Picrophilus oshimae optimum p. H <1 and dead at p. H>4!! Isolated from Japanese volcanic crater; can live in 1 M sulfuric acid – Alkalophiles optimal p. H > 8. 5

Extremophiles challenges • Thermophiles – high temperature – Floppy proteins, leaky membranes • Psychro-philes/trophs – low temperature – Rigid proteins and sludgy membranes • Acidophiles/Alkalophiles - low or high p. H – Floppy proteins AGAIN! • Halophiles - high salt – Dehydration – why is this a problem?

Extremophile survival strategies • Thermophiles – high temperature – Rigidify membranes - Saturate your fatty acids! – Protect protein structure – increase bonds between aas • Amino acid sequence; # and position of bonds structure • Psychro-philes/trophs – low temperature – Loosen membranes – Unsaturate your fatty acids! – Proteins are more flexible • Amino acid sequence; # and position of bonds structure • Acidophiles/Alkalophiles - low or high p. H – Pump H+ into or out of the cell – Produce compounds that act as p. H buffers • Halophiles - high salt – Match the outside; increase internal solute concentration

Water and osmotic pressure • Water required but what’s in it matters too (salt, sugar) • Most cells – [solute] ~ 1%; this solution would be isotonic • hypotonic solution (“too much water”, high osmotic pressure) water rushes into cell causing osmotic lysis – What protects many bacteria? • hypertonic (high salt or sugar) water rushes out of the cell causing plasmolysis – which is why high salt, sugar can preserve food (immortal twinkies) • Obligate halophiles require high osmotic pressure – Marine bacteria ~3% – Extreme halophiles ≥ 9% (Dead Sea, Utah’s salt flats) • Halotolerant: withstand up to 10% eg. Staphylococcus WHY?

The Effect of Oxygen (O 2) on Growth Like water, need for oxygen is complicated We need it – why? Some microbes don’t – how do they survive? Early earth likely had little oxygen, microbes could not have tolerated it Strict anaerobes more ancestral A pathogenic anaerobe from today? Measure oxygen requirement with “deep” culture Boil agar to remove oxygen, cool, add culture, solidify Where does the organism thrive? Table 6. 1

Oxygen detox • Reactive Oxygen Species – Using O 2 in aerobic respiration reactive oxygen species (ROS) as by-products • Includes superoxide (O 2 -) and hydrogen peroxide (H 2 O 2) – Damage cell components • Many organisms have enzymes to detoxify ROS – Most organisms growing in oxygen have • Superoxide dismutase: Converts superoxide to O 2 and H 2 O 2 • Catalase or peroxidase: converts H 2 O 2 to H 2 O +/- O 2 – Exception: aerotolerant anaerobes • SOD only; can be a useful diagnostic test – Obligate anaerobes usually lack all

Why? Because oxygen is toxic • Superoxide free radicals: O 2– Used as antimicrobials in the lysosome of phagocytes superoxide dismutase Superoxide dismutase enzyme

Then what? H 2 O 2 is still dangerous… • Catalase: : 2 H 2 O 2 2 H 2 O + O 2 • Peroxidase: H 2 O 2 + 2 H+ 2 H 2 O • Q: what is catalase? What does positive catalase test tell you?

Different groups have different enzymes Predict what you would expect…

Microbes need nutrients • Chemistry review • Most important elements – CHONPS • Main groups biological molecules – Organic C-C-C • Lipid • Sugar • Protein – Inorganic • Ions, gases Distinguish species by WHERE they get their chemicals

Nutrients • Require nutrients to synthesize cell components – Lipid membranes, cell walls, proteins, nucleic acids – Subunits: sugars, amino acids, nucleotides • Prokaryotes exhibit metabolic diversity – Where do they get their energy and materials? – What can they make from scratch? – What do they need to be supplied? – What’s available in their ecological niche?

Chemical Requirements • Carbon – ½ dry weight of the cell – It’s IN everything: protein, lipid, carbs, DNA, ATP – C-C bonds contain stored energy – Where do they get it? Distinguishes major groups – Heterotrophs use organic carbon sources – Autotrophs use CO 2 carbon fixation

Chemical Requirements • Nitrogen – What macromolecules contain N? – amino acids and proteins – Most bacteria decompose proteins – Some bacteria use NH 4+ or NO 3– – A few bacteria use N 2 in nitrogen fixation

Chemical Requirements • Sulfur – In amino acids, thiamine, and biotin – Most bacteria decompose proteins – Some bacteria use sulfate (SO 42–) or H 2 S • Phosphorus – In DNA, RNA, ATP, and membranes – Phosphate (PO 43–) is a source of phosphorus QUESTION: If bacterial cells were given a sulfur source containing radioactive sulfur ( 35 S) in their culture media, in what molecules would the 35 S be found in the cells?

Chemical Requirements • Trace elements – Inorganic elements required in small amounts – Found at high enough levels in tap water – Usually as enzyme cofactors – cobalt, zinc, copper, molybdenum, manganese

Chemical Requirements • Growth factors – Some microbes cannot synthesize certain molecules • Amino acids, vitamins, purines, pyrimidines • Only grow if these growth factors are available – Biosynthetic diversity • E. coli synthesizes all cellular components from glucose, has wide metabolic capabilities • Neisseria unable to synthesize many, requires numerous growth factors • Termed fastidious: have complicated nutritional requirements • Why do these differences exist? • Which macromolecule class reflects these differences? ? • What does this mean for us in the lab? ?


Four questions • • What are the principles of microbial growth? What conditions do microbes need to grow? How can we grow microbes in the lab? How can we measure growth?

Growing microbes in the lab • Culture medium: Nutrients prepared for microbes – Your examples? ? • Sterile: No living microbes (autoclave – high heat, P) – How do you maintain this? ? • Inoculum: Introduction of microbes into medium – Last lab what was the last inoculation you performed? • Culture: Microbes growing in/on culture medium – Difference pure vs. mixed? ?

Growing microbes in the lab • Types of culture media – Complex media • rich, variety of ingredients • Exact composition highly variable • Often a digest of proteins Which would you use to culture an unknown? ? – Chemically defined media • Exact amounts of pure chemicals • Used for controlled experiments • Solid (Fannie Hess’ agar) – Complex polysaccharide but not metabolized – Liquefies at 100°C, solidifies at ~40°C – Petri dish, slants, deeps

Exact chemical composition is known

: Extracts and digests of yeasts, meat, or plants

So many media available • Yet some medically important microbes, and most environmental ones, have not yet been grown in laboratory
Special types • Useful for identifying /isolating specific species – Differential media contains substance that microbes change in identifiable way (like a differential stain) – Selective media inhibits growth of certain species, encourage desired microbes Your examples? ?

Differential Media • Make it easy to distinguish colonies of different microbes not just a color change Figure 6. 9

Media may be both selective and differential • MSA – mannitol salt agar: 7. 5% salt, mannitol, p. H indicator – Kills most species but not Staphylococcus – halotolerant (skin) – p. H indicator distinguishes aureus from epidermidis (difference in mannitol metabolism) p. H indicator yellow =? Why? Figure 6. 10

Other considerations • Temperature – Appropriate incubator (usually 37 C) – First thing you’ll determine for your unknown!! • Atmosphere – Special apparatus – We’ll check oxygen preferences but limited… assume all lab strains are what?

Atmospheric Conditions • Aerobic – Most obligate aerobes and facultative anaerobes can be incubated in room air (~20% O 2) • Broth cultures shaken to provide maximum aeration – Many medically important bacteria (e. g. , Neisseria, Haemophilus) grow best with increased CO 2 • Some are capnophiles, meaning require increased CO 2 • One method is to incubate in candle jar • Microaerophilic – Require lower O 2 concentrations than achieved by candle jar • Can incubate in gastight container with chemical packet • Chemical reaction reduces O 2 to 5 -15% • What procedure was this? ?

Anaerobic Culture Methods Anaerobic containers - if microbe can tolerate brief O 2 exposures; medium with reducing agent (eg. sodium thioglycolate) to reduce O 2 to water Anaerobic chamber - provides more stringent approach Anaerobic Jar Anaerobic Chamber

Pure Cultures • Pure culture: contains only one species or strain • Colony: population of cells arising from a single cell or spore or group of attached cells • A colony is often called a colony-forming unit (CFU) • The streak plate method used to isolate pure cultures
The Streak Plate Method Why does a colony not grow to an infinite size, or at least fill the Petri plate? Figure 6. 11

Four questions • • What are the principles of microbial growth? What conditions do microbes need to grow? How can we grow microbes in the lab? How can we measure growth?

Measuring Microbial Growth Direct Methods • Dilution plate counts • Direct count Indirect Methods • Turbidity (spec) • Dry weight

Direct Microscopic Count Figure 6. 20

Plate Counts: CFU Figure 6. 17

Serial Dilutions Examples… 1 ml gives you 10 colonies. What’s the concentration? OK so what if you put 0. 1 ml instead and got 10 colonies. What’s the original conc? What if you put 0. 1 ml of a 1: 100 dilution and got 10 colonies… Figure 6. 16

Plate Counts: CFU • Plate known volumes of serial dilutions, incubate, count colonies on plates with 30 -300 (CFUs) 34 count? x 10, 000/1 ml = 340, 000/ml Which one would you How do you do the math? Figure 6. 16

Turbidity – very common indirect spectrophotometer Figure 6. 21

Other indirect methods • Measuring Biomass – Total Weight can be measured • Tedious and time-consuming • Typically only used for filamentous organisms that do not readily separate into individual cells for valid plate counts • Cells in liquid spun to pellet; pellet is dried, then weighed • Detecting Cell Products – Many but in lab you will use: – p. H indicators to detect acid or alkalinity – Durham tubes (inverted tubes) to trap gas

Prokaryotic Growth in Nature • Microorganisms historically studied in laboratory • But dynamic, complex conditions in nature have profound effect on microbial growth, behavior – Cells sense changes, adjust to surroundings – Synthesize compounds useful for growth – Can live singly or… ? ? • Biofilms: Mixed, polysaccharide-coated communities • Biofilms near you: slipperiness of rocks in stream, slimy ‘gunk’ in sink drains, scum in toilet bowls, dental plaque

Biofilms • Biofilms have characteristic architectures – Channels through which nutrients and wastes pass – Cells communicate by synthesizing chemical signals From Tortora 10 th edition (Pearson) No microbes were harmed in the making of this biofilm From Tortora 10 th edition (Pearson)

Implications • Biofilms have important implications – Dental plaque leads to tooth decay, gum disease – Most infections (e. g. ear infections, cystic fibrosis) – Industrial concerns: accumulations in pipes, drains – Biofilm structure shields microbes growing within • May be hundreds of times more resistant to microbicides – Biofilms can also be helpful • Bioremediation, wastewater treatment

Mixed Microbial Communities • Prokaryotes regularly grow in close association – Interactions can be cooperative • Can foster growth of species otherwise unable to survive – Strict anaerobes can grow in mouth if others consume O 2 – Metabolic waste of one can serve as nutrient for other – Interactions often competitive • Some synthesize toxic compounds to inhibit competitors
- Slides: 68